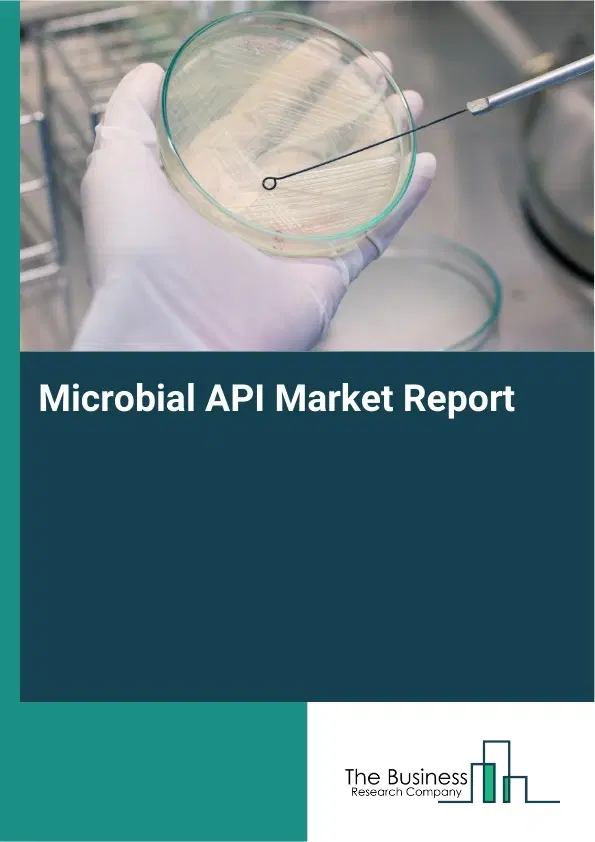
Global Microbial API Market Report 2026 Global Microbial API Market Report 2026

Microbial API Market Report 2026
Microbial API Market Report 2026
Global Outlook – By Type (Peptide, Protein, Small Molecule, Vaccine), By Host (Bacterial, Fungal), By Site (In-House, Outsourced), By Molecule (Innovative, Generic), By End-Use (Pharmaceutical Companies, Biopharmaceutical Companies, Other End-Uses) – Market Size, Trends, Strategies, and Forecast to 2035
Microbial API Market Overview
• Microbial API market size has reached to $67.52 billion in 2025 • Expected to grow to $95.49 billion in 2030 at a compound annual growth rate (CAGR) of 7% • Growth Driver: Rising Chronic Conditions Fuel Growth Of The Microbial API Market • Market Trend: Advancements In Excipient Development Driving Innovation In The Microbial API Market • Asia-Pacific was the largest region in 2025.What Is Covered Under Microbial API Market?
Microbial API refers to active pharmaceutical Ingredients produced through microbial fermentation or biotransformation processes, using microorganisms like bacteria, yeast, and fungi to create essential compounds such as antibiotics and vitamins, which are important in the pharmaceutical industry due to their scalability, cost-effectiveness, and ability to perform complex biochemical reactions. The main microbial APIs are antibodies, peptides, proteins, small molecules, and vaccines. An antibody is a protein produced by the immune system that binds to specific molecules called antigens. It has different types of hosts including mammalian, bacterial, and fungal, and different sites such as in-house and outsourced. It has both innovative and generic molecules and is used by several end-users including pharmaceutical companies, biopharmaceutical companies, and others.
What Is The Microbial API Market Size and Share 2026?
The microbial api market size has grown strongly in recent years. It will grow from $67.52 billion in 2025 to $72.79 billion in 2026 at a compound annual growth rate (CAGR) of 7.8%. The growth in the historic period can be attributed to longstanding use of microbial fermentation in antibiotic production, cost advantages over chemical synthesis routes, established microbial strains for api manufacturing, growing pharmaceutical demand for vitamins and antibiotics, scalability of microbial bioprocesses.What Is The Microbial API Market Growth Forecast?
The microbial api market size is expected to see strong growth in the next few years. It will grow to $95.49 billion in 2030 at a compound annual growth rate (CAGR) of 7.0%. The growth in the forecast period can be attributed to increasing demand for biologics and complex apis, expansion of vaccine manufacturing capacity, rising focus on sustainable pharmaceutical production, growth of contract manufacturing organizations, continued demand for affordable generic apis. Major trends in the forecast period include growing adoption of microbial fermentation for api production, increasing outsourcing of microbial api manufacturing to cdmos, rising demand for antibiotic and vaccine apis, shift toward cost-effective and scalable bioprocessing methods, expansion of generic microbial apis in global markets.Global Microbial API Market Segmentation
1) By Type: Peptide, Protein, Small Molecule, Vaccine 2) By Host: Bacterial, Fungal 3) By Site: In-House, Outsourced 4) By Molecule: Innovative, Generic 5) By End-Use: Pharmaceutical Companies, Biopharmaceutical Companies, Other End-Uses Subsegments: 1) By Peptide: Therapeutic Peptides, Diagnostic Peptides 2) By Protein: Recombinant Proteins, Native Proteins 3) By Small Molecule: Antibiotics, Antifungals, Antivirals 4) By Vaccine: Bacterial Vaccines, Viral VaccinesWhat Is The Driver Of The Microbial API Market?
The rising prevalence of chronic conditions is expected to propel the growth of the microbial API market going forward. Chronic conditions refer to long-lasting diseases or health disorders that persist over time and often require ongoing treatment and management. The prevalence of chronic conditions is increasing due to aging populations, sedentary lifestyles, poor diets, environmental changes, and improved disease detection and diagnosis. The microbial API market supports the management of chronic conditions by leveraging therapeutically active compounds derived from microorganisms to develop effective and targeted treatments. For instance, in February 2024, according to the World Health Organization, a Switzerland-based intergovernmental organization, global cancer cases were projected to exceed 0.035 billion by 2050, representing a 77% increase from an estimated 0.02 billion cases in 2022. Therefore, the rising prevalence of chronic conditions is driving the growth of the microbial API industryKey Players In The Global Microbial API Market
Major companies operating in the microbial api market are BASF SE, Lonza Group AG, Evonik Industries AG, Royal DSM NV, Catalent Inc., Patheon, Siegfried Ltd., Recipharm AB, Xellia Pharmaceuticals, Shandong Lukang Pharmaceutical Co. Ltd., Tianjin Tianyao Pharmaceuticals Co. Ltd., Henan Topfond Pharmaceutical Co. Ltd., CSPC Pharmaceutical Group Ltd., Dr. Reddy's Laboratories Ltd., Aurobindo Pharma Limited, Teva Pharmaceutical Industries Ltd., Boehringer Ingelheim GmbH, AbbVie Inc., Sanofi S.A., Merck & Co. Inc.Global Microbial API Market Trends and Insights
Major companies operating in the microbial API market are focusing on developing novel API-supporting products such as pharmaceutical excipients to enhance drug efficacy, improve formulation stability, and meet evolving regulatory and manufacturing standards. Excipients refer to inactive substances incorporated alongside active pharmaceutical ingredients to support stability, optimize solubility, improve bioavailability, enable efficient manufacturing, and enhance the overall therapeutic performance of finished drug products. For instance, in October 2023, Clariant, a Switzerland-based chemical company, launched a new range of VitiPure excipients designed to improve the stability and solubility of APIs, offering formulation solutions suitable for oral, topical, and parenteral applications. These excipients provide effective carrier systems for challenging drug modalities, including biologics and mRNA-based therapies, supporting improved delivery, enhanced bioavailability, and greater formulation flexibility for sensitive pharmaceutical products.What Are Latest Mergers And Acquisitions In The Microbial API Market?
In July 2023, Sartorius Stedim Biotech (Sartorius) S.A a Germany-based bioprocessing company, acquired Polyplus-transfection SA for an undisclosed amount. This acquisition strengthens Sartorius’s upstream reagent and plasmid-DNA capabilities by integrating Polyplus’s transfection technologies, which serve as key inputs and raw materials for viral-vector and nucleic-acid manufacturing workflows that overlap with microbial and fermentation-based API production. Polyplus-Transfection SA is a France-based company that provides microbial manufacturing services for Active Pharmaceutical IngredientsRegional Insights
Asia-Pacific was the largest region in the microbial API market in 2025. The regions covered in this market report are Asia-Pacific, South East Asia, Western Europe, Eastern Europe, North America, South America, Middle East, Africa. The countries covered in this market report are Australia, Brazil, China, France, Germany, India, Indonesia, Japan, Taiwan, Russia, South Korea, UK, USA, Canada, Italy, Spain.What Defines the Microbial API Market?
The microbial API market consists of sales of, glycerin, and hydrolyzed yeast protein, salvia sclarea oil, allantoin and other related products. Values in this market are ‘factory gate’ values, that is the value of goods sold by the manufacturers or creators of the goods, whether to other entities (including downstream manufacturers, wholesalers, distributors and retailers) or directly to end customers. The value of goods in this market includes related services sold by the creators of the goods.How is Market Value Defined and Measured?
The market value is defined as the revenues that enterprises gain from the sale of goods and/or services within the specified market and geography through sales, grants, or donations in terms of the currency (in USD unless otherwise specified). The revenues for a specified geography are consumption values that are revenues generated by organizations in the specified geography within the market, irrespective of where they are produced. It does not include revenues from resales along the supply chain, either further along the supply chain or as part of other products.What Key Data and Analysis Are Included in the Microbial API Market Report 2026?
The microbial api market research report is one of a series of new reports from The Business Research Company that provides market statistics, including industry global market size, regional shares, competitors with the market share, detailed market segments, market trends and opportunities, and any further data you may need to thrive in the microbial api industry. The market research report delivers a complete perspective of everything you need, with an in-depth analysis of the current and future state of the industry.Microbial API Market Report Forecast Analysis
| Report Attribute | Details |
|---|---|
| Market Size Value In 2026 | $72.79 billion |
| Revenue Forecast In 2035 | $95.49 billion |
| Growth Rate | CAGR of 7.8% from 2026 to 2035 |
| Base Year For Estimation | 2025 |
| Actual Estimates/Historical Data | 2020-2025 |
| Forecast Period | 2026 - 2030 - 2035 |
| Market Representation | Revenue in USD Billion and CAGR from 2026 to 2035 |
| Segments Covered | Type, Host, Site, Molecule, End-Use |
| Regional Scope | Asia-Pacific, Western Europe, Eastern Europe, North America, South America, Middle East, Africa |
| Country Scope | The countries covered in the report are Australia, Brazil, China, France, Germany, India, ... |
| Key Companies Profiled | BASF SE, Lonza Group AG, Evonik Industries AG, Royal DSM NV, Catalent Inc., Patheon, Siegfried Ltd., Recipharm AB, Xellia Pharmaceuticals, Shandong Lukang Pharmaceutical Co. Ltd., Tianjin Tianyao Pharmaceuticals Co. Ltd., Henan Topfond Pharmaceutical Co. Ltd., CSPC Pharmaceutical Group Ltd., Dr. Reddy's Laboratories Ltd., Aurobindo Pharma Limited, Teva Pharmaceutical Industries Ltd., Boehringer Ingelheim GmbH, AbbVie Inc., Sanofi S.A., Merck & Co. Inc. |
| Customization Scope | Request for Customization |
| Pricing And Purchase Options | Explore Purchase Options |
Frequently Asked Questions
The Microbial API market was valued at $67.52 billion in 2025, increased to $72.79 billion in 2026, and is projected to reach $95.49 billion by 2030.
request a sample hereThe global Microbial API market is expected to grow at a CAGR of 7.0% from 2026 to 2035 to reach $95.49 billion by 2035.
request a sample hereSome Key Players in the Microbial API market Include, BASF SE, Lonza Group AG, Evonik Industries AG, Royal DSM NV, Catalent Inc., Patheon, Siegfried Ltd., Recipharm AB, Xellia Pharmaceuticals, Shandong Lukang Pharmaceutical Co. Ltd., Tianjin Tianyao Pharmaceuticals Co. Ltd., Henan Topfond Pharmaceutical Co. Ltd., CSPC Pharmaceutical Group Ltd., Dr. Reddy's Laboratories Ltd., Aurobindo Pharma Limited, Teva Pharmaceutical Industries Ltd., Boehringer Ingelheim GmbH, AbbVie Inc., Sanofi S.A., Merck & Co. Inc. .
request a sample hereMajor trend in this market includes: Advancements In Excipient Development Driving Innovation In The Microbial API Market. For further insights on this market.
request a sample hereAsia-Pacific was the largest region in the microbial API market in 2025. The regions covered in the microbial api market report are Asia-Pacific, South East Asia, Western Europe, Eastern Europe, North America, South America, Middle East, Africa.
request a sample here